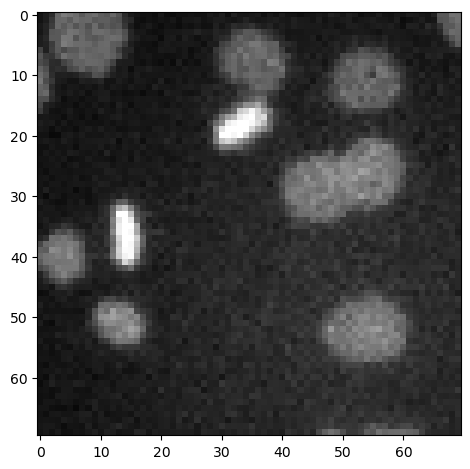
../_images/7965ce710e547039cf2bfd6f886f9e6d38b6871ba74d6654aa2ead048f7a6139.png

Binarización de Imágenes#
Al binarizar una imagen, producimos una imagen que tiene solo dos valores: Verdadero y Falso. También pueden contener el valor 0, por ejemplo para el fondo, y cualquier otro valor para el primer plano.
import numpy as np
from skimage.io import imread, imshow
from skimage.filters import gaussian
Usamos esta imagen de ejemplo de núcleos.
image_nuclei = imread('../../data/mitosis_mod.tif')
imshow(image_nuclei)
<matplotlib.image.AxesImage at 0x1dcf6b5dbe0>
Umbralización de Imágenes#
La técnica de binarización más común es la umbralización. Aplicamos un umbral para determinar qué píxeles están por encima de cierta intensidad de píxel y cuáles están por debajo.
image_binary = image_nuclei > 60
imshow(image_binary)
<matplotlib.image.AxesImage at 0x1dcf6bb09a0>

Mejorando los resultados de binarización#
A veces, los resultados de la binarización aparecen pixelados. Esto se puede mejorar aplicando un filtro antes de umbralizar la imagen.
image_denoised = gaussian(image_nuclei, sigma=1, preserve_range=True)
imshow(image_denoised, cmap='Greys_r')
C:\Users\haase\mambaforge\envs\bio39\lib\site-packages\skimage\io\_plugins\matplotlib_plugin.py:150: UserWarning: Float image out of standard range; displaying image with stretched contrast.
lo, hi, cmap = _get_display_range(image)
<matplotlib.image.AxesImage at 0x1dcf6c48640>

image_binary2 = image_denoised > 60
imshow(image_binary2)
<matplotlib.image.AxesImage at 0x1dcf7d61040>

